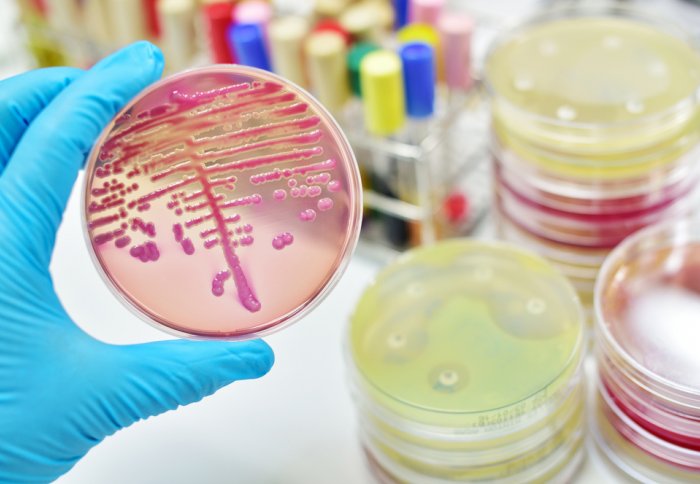
The new test could mean doctors no longer need to wait to grow bacteria to diagnose an infection

£14m EU project to aid meningitis diagnosis and cut antibiotic use
by Kate Wighton
The new rapid test could mean doctors no longer need to wait to grow bacteria to diagnose an infection
An international team of doctors are aiming to develop a rapid test to allow medics to quickly identify bacterial infection in children.
The hope is the £14 m project, funded by the EU, will not only allow medical staff to reduce the number of unnecessary antibiotics - but it could also quickly identify deadly cases of meningitis, sepsis and other life-threatening bacterial infections.
Our current methods do not allow doctors to reliably distinguish between life-threatening bacterial infection and trivial viral illness
– Professor Mike Levin
Project lead
In the new project, called PERFORM, the team will build on previous research that showed bacterial illnesses can be identified by a particular patterns of genes and proteins.
Mike Levin, Professor of International Child Health at Imperial College London, who leads the new project explained: “Rather than attempting to identify the bacteria, which has been the focus of most previous tests for bacterial infection, we believe bacterial infection can be recognised by the pattern of genes and proteins activated by the child’s immune system in response to the infection.”
During the five-year project the team will study around 60,000 children across Europe and West Africa who arrive at hospitals and clinics with a high fever.
At the moment, when a child arrives at a surgery or hospital with fever, doctors have no quick method of distinguishing whether the child is suffering from bacterial or viral illness. Diagnosis relies instead on taking a sample of blood or spinal fluid, and seeing if bacteria grow in this sample. However this can take more than 48 hours.
Differentiating between viruses and bacteria is crucially important. Although viral infections are much more common than bacterial infections, the latter are far more dangerous, and lead to a deadly conditions such as meningitis, septicaemia and pneumonia.
Therefore as a precaution, doctors often give antibiotics immediately to children with high fever – before the test results are available to confirm whether the child is suffering from a bacterial or viral infection.
Professor Levin added: “Fever is one of the most common reasons children are brought to medical care. While most episodes of high fever in children are due to a viral illness – which will often get better on its own - hidden amongst them are life-threatening bacterial infections. Our current methods do not allow doctors to reliably distinguish between life-threatening bacterial infection and trivial viral illness.
As a result, thousands of children each day worldwide undergo investigations such as lumbar puncture, x-rays and blood tests and are treated with antibiotics while awaiting the results of investigations to rule out bacterial infection.”
Antibiotics are powerless against viral infections, but because there is no reliable method to distinguish the rare cases of bacterial infection from the many children with viral infections, many receive unnecessary treatment with antibiotics. This frequent, unnecessary, use of antibiotics for common viral infections, contributes to the growing threat of antibiotic resistance. A recent Government report warned antibiotic resistance would kill one person every three seconds by 2050.
Professor Levin added: “Lack of an accurate, reliable and rapid test to distinguish bacterial infections from the vastly more common viral infections is a major factor leading to widespread prescription of antibiotics in both hospitals and in the community. Indeed, the Government’s O’Neill report recently highlighted the urgent need for the development of these rapid tests.”
Furthermore, the lack of a quick test to distinguish between bacterial and viral infections mean some potentially dangerous bacterial infections can be missed, explained Professor Levin: “Every year many children are sent away from Accident & Emergency departments or GP surgeries because the medical team thinks they have a viral infection, when in fact they are suffering from life-threatening bacterial infections - which are only diagnosed too late.”
During the five year project, funded by the European Commission’s Horizon 2020 programme, the international team will study around 60,000 children who arrive at hospitals across Europe and West Africa with fever. The team includes groups from Oxford, Liverpool, Newcastle, Spain, Austria, Germany, The Netherlands, Greece, Slovenia, Latvia , the Gambia and Switzerland, as well as the biotechnology companies Micropathology Ltd UK and bioMérieux, France.
Federico Martinón-Torres, Professor of Paediatrics from the University of Santiago de Compostela, Spain who leads the clinical recruitment programme said: “The PERFORM research programme will build on previous successful collaboration between paediatricians and scientists across Europe. The large numbers of children with infection that we need to study can only be achieved through collaboration across Europe. By joining efforts in recruiting patients to research studies and linking the powerful new genetic and proteomic research methods available across Europe our progamme will make a major contribution to one of the world’s most important problems – the growing problem of antimicrobial resistance”.
The PERFORM grant is one of the largest awarded by the European Commission’s Horizon 2020 Health Programme in 2016 and aims to bring novel new diagnostics into clinical use and improve management of febrile children within the five year period.
Article text (excluding photos or graphics) © Imperial College London.
Photos and graphics subject to third party copyright used with permission or © Imperial College London.
Reporter
Kate Wighton
Communications Division